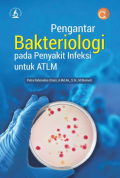
Pengantar Bakteriologi pada Penyakit Infeksi untuk ATLM

Koleksi




Hasil Pencarian
Ditemukan 12 dari pencarian Anda melalui kata kunci: Subject : "Bakteri"
Permintaan membutuhkan 0,23037 detik untuk selesai
Informasi
Akses Katalog Publik Daring - Gunakan fasilitas pencarian untuk mempercepat penemuan data katalog

Perpustakaan UMA
Online Public Access Catalog (OPAC)Perpustakaan UMA Terakreditasi A Perpustakaan Nasional Republik Indonesia
Sejarah Perpustakaan Universitas Medan Area dimulai dari berdirinya Universitas Medan Area (UMA) pada tahun 1983, saat ini terdapat 50.000 lebih koleksi yang tersedia di Perpustakaan pusat maupun Perpustakaan Fakultas.
Info selengkapnya